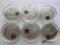
BURSZTYNOWY SZLAK 6 MONET MENNICZE OKSYDA

Archiwum Alle > Kolekcje > Numizmatyka
- Afryka (24604)
- Akcesoria (45245)
- Ameryka Pn. i Pd. (70326)
- Antyczne (11370)
- Australia i Oceania (22457)
- Azja (42459)
- Europa (249276)
- Islam (1638)
- Literatura (14955)
- Monety zastępcze (23662)
- Monety złote (5294)
- Polska do 1945 (72525)
- Polska po 1945 (167217)
- Powiązane z Polską (5402)
- Pozostałe (44265)
- Srebro lokacyjne (2924)
- Średniowieczne (2809)
- Talary (1573)
- Tematyczne (24704)
- Wolne Miasto Gdańsk (2312)
CuNiAu TYGRYS TASMAŃSKI trójwymiar 2011 NOWE

* MONETY KOLEKCJONERSKIE KONTAKT * te.: 604 [zasłonięte] 088 * e-mail: PRZESYŁKA * towar zabezpieczony * pakowany w koperty bąbelkowe * kupując kilka przedmiotów oszczędzasz na wysyłce INFORMACJE * przed zakupem przeczytaj zakładkę O MNIE * wpłata na k…
kup teraz: 199zł
Koniec: 09-07-2012
Koniec: 09-07-2012
Celebrate Australia Adelaide ANDA Tasmanian 2011

tel.: +48 [zasłonięte]-376-326 MBank 51 1140 [zasłonięte] 2[zasłonięte]0040002 [zasłonięte] 353308 Paypal: [zasłonięte]@magikos-coins.pl Paypal payment +4% WYSYŁKA CAŁY ŚWIAT za wyjątkiem INDII INTERNATIONAL SHIPPING without INDIA ! Wysyłka następuje kurierem UPS lub Pocztą Polską z ubezpieczeni…
kup teraz: 409zł
Koniec: 09-07-2012
Koniec: 09-07-2012
Rekin White Shark 2007 Tuvalu Deadly&Dangerous

tel.: +48 [zasłonięte]-376-326 przesyłka zostanie wysłana do Państwa w przeciągu 7 dni roboczych chyba że opis aukcji stanowi inaczej Poczta Polska - 9.99 zł. Kurier - 30 zł. Tuvalu 2007 REKIN BIAŁY Deadly & Dangerous Kolejna Moneta z serii Zabójcz…
kup teraz: 899zł
Koniec: 09-07-2012
Koniec: 09-07-2012
Discover Australia 2012 ZLOTO AU 5 x 1/2 OZ

tel.: +48 [zasłonięte]-376-326 MBank 51 1140 [zasłonięte] 2[zasłonięte]0040002 [zasłonięte] 353308 Paypal payment +4% WYSYŁKA CAŁY ŚWIAT za wyjątkiem INDII INTERNATIONAL SHIPPING without INDIA ! Wysyłka następuje kurierem UPS lub Pocztą Polską z ubezpieczeniem na pełną kwotę - według cen…
kup teraz: 25 499zł
Koniec: 09-07-2012
Koniec: 09-07-2012
Okna Niebios Katedra Św. Izaaka 2012

tel.: +48 [zasłonięte]-376-326 Paypal: [zasłonięte]@magikos-coins.pl Paypal payment +4% WYSYŁKA CAŁY ŚWIAT za wyjątkiem INDII INTERNATIONAL SHIPPING without INDIA ! Wysyłka następuje kurierem UPS lub Pocztą Polską z ubezpieczeniem na pełną kwotę - według cennika . Ko…
kup teraz: 919zł
Koniec: 09-07-2012
Koniec: 09-07-2012
JellyFish Meduza 2011 Tuvalu Deadly&Dangerous

tel.: +48 [zasłonięte]-293-326 przesyłka zostanie wysłana do Państwa w przeciągu 7 dni roboczych chyba że opis aukcji stanowi inaczej Poczta Polska - 9.99 zł. Kurier - 30 zł. Tuvalu 2011 JELLYFISH Deadly & Dangerous Kolejna Moneta z serii Zabójcze …
kup teraz: 649zł
Koniec: 09-07-2012
Koniec: 09-07-2012
Ośmiornica 2008 Tuvalu Deadly&Dangerous

tel.: +48 [zasłonięte]-376-326 przesyłka zostanie wysłana do Państwa w przeciągu 7 dni roboczych chyba że opis aukcji stanowi inaczej Poczta Polska - 9.99 zł. Kurier - 30 zł. Tuvalu 2008 OŚMIORNICA Deadly & Dangerous Kolejna Moneta z serii Zabójcze…
kup teraz: 1 199zł
Koniec: 09-07-2012
Koniec: 09-07-2012
Matka Boska Ostrobramska Palau 2009 Srebro/zloto

tel.: +48 [zasłonięte]-376-326 [zasłonięte] 68 11 2004 [zasłonięte] 0[zasłonięte]000[zasłonięte] 7519 przesyłka zostanie wysłana do Państwa w przeciągu 7 dni roboczych chyba że opis aukcji stanowi inaczej Poczta Polska - 12 zł. Kurier - 30 zł. Zapraszam do zakupu: Matka Boska Ostrobramska Palau 2…
kup teraz: 299zł
Koniec: 09-07-2012
Koniec: 09-07-2012
Australia Perth Rok Smoka 10Oz 5Oz 2Oz 1Oz 1/2Oz

tel.: +48 [zasłonięte]-376-326 [zasłonięte] 51 11 2004 [zasłonięte] 0[zasłonięte]000[zasłonięte] 3908 Paypal payment + 4 % WYSYŁKA CAŁY ŚWIAT za wyjątkiem INDII INTERNATIONAL SHIPPING without INDIA ! Wysyłka następuje kurierem UPS Pocztą Polską z ubezpieczeniem na pełną kwotę - według cennika . K…
kup teraz: 7 400zł
Koniec: 09-07-2012
Koniec: 09-07-2012
Ag Skarby Australii PERŁY Australia 2011 DOSTĘPNE

* MONETY KOLEKCJONERSKIE KONTAKT * te.: 604 [zasłonięte] 088 * e-mail: PRZESYŁKA * towar zabezpieczony * pakowany w koperty bąbelkowe * kupując kilka przedmiotów oszczędzasz na wysyłce INFORMACJE * przed zakupem przeczytaj zakładkę O MNIE * wpłata na k…
kup teraz: 899zł
Koniec: 09-07-2012
Koniec: 09-07-2012
Tuvalu 2012 1$ Legendarne smoki - CHIŃSKI SMOK

dominusarx.pl - numizmatyczny dom aukcyjny
kup teraz: 549zł
Koniec: 09-07-2012
Koniec: 09-07-2012
Fiji 2012 10$ APOKALIPSA Kalendarz Majów

dominusarx.pl - numizmatyczny dom aukcyjny
kup teraz: 849zł
Koniec: 09-07-2012
Koniec: 09-07-2012
Niue Island-1 NZD-Lilie-Lilium armenum

Moneta "Lilium armenum" jest jedna z 3 monet poświeconych gatunkom lilii pochodzących z róznych regionow świata. "Lilium armenum" to roślina występująca w Armenii, głównie w rejonie Kotayk. Rok emisji 2012 Emitent Niue Island Nominał 1 …
kup teraz: 332zł
Koniec: 09-07-2012
Koniec: 09-07-2012
Cook I 5$ ROBERT MITCHUM 2012 Ag Kolor NEW!

e-mail:[zasłonięte]@gmail.com tel. +487[zasłonięte]16315 tel. +487[zasłonięte][zasłonięte]16317zł-kurier wpłata na konto MULTIBANK,PKO BP przy odbiorze wpłaty do 7dni od zakończenia aukcji (ewentualnie inaczej po uzgodnieniu) jako sprzedający wystawiamy komentarz drudzy kupując ki…
kup teraz: 299zł
Koniec: 09-07-2012
Koniec: 09-07-2012
Australia 2011 1$ 1 Oz Ginger Meggs Komiks

szablon Łukasz Nieczaj REGON: 221[zasłonięte]080 NIP: 593[zasłonięte]230-41 81-393 Gdynia ul.Jana Kilińskiego 14A/3 email: [zasłonięte]@wp.pl tel: 513-[zasłonięte]-813 Przedmiot wysyłamy do 4 dni roboczych, chyba że w aukcji będzie podane inaczej. Na wpłatę czekamy do 7 dni po wygr…
kup teraz: 649zł
Koniec: 09-07-2012
Koniec: 09-07-2012
Legendy Legenda Smoków 2 TUVALU 2012 Chinski Smok

tel.: +48 [zasłonięte]-376-326 Paypal payment + 4% INTERNATIONAL SHIPPING Koszt podstawowy list polecony priorytetowy- 12 zł. Ubezpieczenie 1 zł na każde 50 zł zadeklarowanej wartości dodane do kosztu podstawowego. Wysyłka kurierska 25 zł.+ew. koszty ubezpiec…
licytacja: 348.33zł
najwyższa: 348.33zł
Koniec: 08-07-2012
najwyższa: 348.33zł
Koniec: 08-07-2012
BURSZTYNOWY SZLAK 6 MONET MENNICZE OKSYDA
Przedmiotem aukcji jest 6 początkowych monet z serii Bursztynowy Szlak . Monety są w stanie menniczym - fotografie przedstawiają licytowane monety. Oferowany komplet składa się z monet: - Kaliningrad, - Gdańsk, - Elbląg, - Wrocław, - Stare Hardisko, …
kup teraz: 910zł
Koniec: 08-07-2012
Koniec: 08-07-2012
KOOKABURRA 1oz 999--2008--POZLACANA!!!!

Witam Kookabura 1oz999 z 2008r,stan monety mennicy.Pozlacana!!!
licytacja: 210zł
najwyższa: 210zł
Koniec: 08-07-2012
najwyższa: 210zł
Koniec: 08-07-2012
Legendy Hollywood- ALUMINIOWE ETUI NA 6 MONET

Legendy Hollywood- ALUMINIOWE ETUI NA 6 MONET Z SERII LEGENDY HOOLYWOOD STAN IDEALNY POLECAM ZAKUP NA POZOSTAŁYCH AUKCJACH ZNAJDZIESZ NIEKTÓRE Z MONET Z TEJ SERII
licytacja: 51.97zł
najwyższa: 51.97zł
Koniec: 09-07-2012
najwyższa: 51.97zł
Koniec: 09-07-2012
1 $ 2009 COOK ISLANDS CUDA NATURY WOLCANO ETNA

piotrek - monety1 PRZEDMIOTEM AUKCJI JEST MONETA- 1 $ 2009 COOK ISLANDS CUDA NATURY. MONETA SREBRZONA Z CERTYFIKATEM. Specyfikacja przedmiotu MONETA-SREBRZONA ŚREDNICA-38MM WAGA-g STAN MONETY-BARDZO DOBRY Z-A-P-R-A-S-Z-A-M D-O L-I-C-Y-T-A-C-J-I ZAPRA…
kup teraz: 55zł
licytacja: 49.99zł
Koniec: 09-07-2012
licytacja: 49.99zł
Koniec: 09-07-2012
WAŻKA - ŚWIAT INSEKTÓW - Palau - srebro 925

WITAM NA MOJEJ AUKCJI Do sprzedania mam monetę z mojej prywatnej kolekcji WAŻKA Aeshna Affinis Druga moneta z serii ŚWIAT INSEKTÓW Kraj: Australia PALAU Rok: 2010 Nakład: 1000 sztuk!!! Nominał: 2 dolary Metal: Srebro .925 Waga: 1/2 Oz (15,55 gram) St…
kup teraz: 179zł
licytacja: 159zł
Koniec: 09-07-2012
licytacja: 159zł
Koniec: 09-07-2012
MELANOCETUS - RYBY GŁĘBINOWE srebro 925

WITAM NA MOJEJ AUKCJI Sprzedaję nadwyżki prywatnej kolekcji MELANOCETUS JOHNSONII HUMPBACK ANGLERFISH Pierwsza moneta z serii RYBY GŁĘBINOWE - DEAP SEA FISH Kraj: Australia PITCAIRN ISLANDS Rok: 2010 Nakład: 1000 sztuk !! Nominał: 2 dolary Metal: Sre…
kup teraz: 180zł
licytacja: 149zł
Koniec: 09-07-2012
licytacja: 149zł
Koniec: 09-07-2012
BŁAZENEK - The Reef - 1/2 Oz srebro 99.9%

WITAM NA MOJEJ AUKCJI Do sprzedania mam monetę z mojej prywatnej kolekcji BŁAZENEK Clownfish Czwarta moneta z serii THE REEF Kraj: Australia THE PERT MINT Rok: 2010 Nakład: 10000 sztuk !!! Nominał: 0.5$ Metal: Srebro .999 Waga: 1/2 Oz (15,55 gram) St…
kup teraz: 199zł
licytacja: 149zł
Koniec: 09-07-2012
licytacja: 149zł
Koniec: 09-07-2012
AUSTRALIA 2011 KOALA 1/10 OZ - SREBRO -

2011 AUSTRALIA 10 CENTOW - MIS KOALA - W GRADINGU FIRMY NGC MS69 1/10 UNCJI SREBRA MONETA W STANIE MENNICZYM MONETA WYBITA STEMPLEM ZWYKLYM I JEST W KAPSLU OCHRONNYM FIRMY NGC Diameter/SREDNICA 20.60 mm Weight/WAGA 0.10 troy oz (3.135 g) Thickness/Gr…
kup teraz: 65zł
Koniec: 08-07-2012
Koniec: 08-07-2012
Cook I 5$ ANITA EKBERG 2012 Ag Kolor NEW!

e-mail:[zasłonięte]@gmail.com tel. +487[zasłonięte]16315 tel. +487[zasłonięte][zasłonięte]16317zł-kurier wpłata na konto MULTIBANK,PKO BP przy odbiorze wpłaty do 7dni od zakończenia aukcji (ewentualnie inaczej po uzgodnieniu) jako sprzedający wystawiamy komentarz drudzy kupując ki…
licytacja: 189zł
najwyższa: 189zł
Koniec: 08-07-2012
najwyższa: 189zł
Koniec: 08-07-2012
